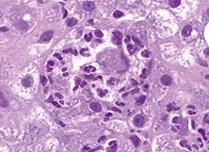
C - Courtoisie Pr. Denis Chatelain, Service Anatomopathologie CHU Amiens- Picardie.

Lien d’intérêts
Pas de lien d’intérêt en relation avec cet article.
Mots-clés
Hépatite alcoolique, corticostéroides, Maddrey score, MELD, Lille model, transplantation hépatique.
Introduction
La maladie du foie liée à l’alcool englobe un spectre de lésions hépatiques allant de la simple stéatose, très fréquente, à l’apparition progressive d’une fibrose hépatique puis d’une cirrhose dans 20 % des cas, avec ensuite ses complications telles que l’hypertension portale, l’insuffisance hépatique et le carcinome hépatocellulaire (1,2). L’hépatite alcoolique (HA) a une présentation histologique caractéristique avec des foyers de nécrose hépatocytaire associés à une infiltration de polynucléaires neutrophiles (PNN), une ballonisation hépatocytaire et la présence de corps de Mallory (figure 1). L’expression clinique est très polymorphe, allant d’une forme peu ou asymptomatique, à une forme d’hépatite alcoolique sévère, se développant chez un patient ayant, dans plus de 80 % des cas, une fibrose avancée ou une cirrhose constituée, déjà connues ou découvertes à cette occasion. Cette forme sévère se manifeste cliniquement par l’apparition rapide d’un ictère dans un contexte de consommation active d’alcool, de signes d’insuffisance hépatocellulaire, d’hypertension portale et d’une encéphalopathie hépatique (2). L’hépatite alcoolique sévère engage le pronostic à court et moyen terme, avec une mortalité proche de 25 % à 1 mois et 50 % à 6 mois (3). En l’absence de traitement la mortalité spontanée évaluée à 28 jours est comprise entre 34,9 % et 44 % (4). L’incidence de l’hépatite alcoolique n’est pas bien connue en France.
La physiopathologie
La physiopathologie de l’hépatite alcoolique est complexe intriquant des mécanismes comme l’augmentation de la perméabilité de la barrière intestinale avec le passage dans la circulation portale puis dans le foie du lipopolysaccharide composant de la paroi des bactéries (LPS), l’activation de l’immunité innée, l’infiltration hépatique par les PNN, la mort de l’hépatocyte par nécrose et/ ou apoptose et la variabilité inter-individuelle des facteurs génétiques. Plus récemment le rôle de la dysbiose intestinale induite par l’alcool a été étudié avec un intérêt croissant.
Dysbiose intestinale et augmentation de la perméabilité intestinale
Le microbiote intestinal (MI) est composé de 1014 micro-organismes. Chaque individu possède son propre microbiote intestinal, stabilisé dans sa composition dès les premières années de la vie. La consommation chronique d’alcool est responsable d’une modification du MI (dysbiose) avec chez l’animal une diminution des phyla Lactobacillus, Bacteroïdetes, Firmicutes, une augmentation des Proteobacteria ainsi qu’une diminution globale de la diversité du microbiote intestinal (5). Chez l’homme la dysbiose existe aussi chez les patients alcooliques avec une diminution des Bacteroïdetes et une augmentation des Enterobacteriacae et des Proteobacteria (6). Cette dysbiose pourrait expliquer des mécanismes de diminution de la couche de mucus participant à la protection des entérocytes (7), une diminution par certaines souches de micro-bactéries de la synthèse de protéines participant à la constitution des jonctions serrées des entérocytes (8), induisant au final l’augmentation de la perméabilité intestinale, expliquant le passage plus fréquent des bactéries dans la circulation portale arrivant ensuite dans le foie. Il a été démontré qu’une transplantation de microbiote de patients ayant une HA à des souris germ free et soumises ensuite à un régime alimentaire de Lieber de Carli enrichi progressivement en alcool, permettait de déclencher une inflammation du foie en comparaison à des souris témoins soumises au même régime mais recevant une transplantation de microbiote intestinal d’un humain sans HA sévère (9). La dysbiose intestinale liée à la consommation d’alcool est donc probablement impliquée dans les processus physiopathologiques de l’HA.
Métabolisme de l’alcool et stress oxydatif
Le métabolisme de l’éthanol génère un stress oxydatif avec la production d’espèces réactives à l’oxygène (ROS). Ainsi la toxicité cellulaire est due à l’acétaldéhyde qui est le principal métabolite de l’alcool produit presque exclusivement par l’alcool déshydrogénase cytosolique (ADH) des hépatocytes, et accessoirement par le cytochrome P450 dans le microsome, ou encore par la catalase dans les peroxysomes (10).
Les autres causes de majoration du stress oxydant sont la peroxydation lipidique sur un foie stéatosique, et une diminution du glutathion mitochondrial et de la S-adénosine méthionine (11) largement consommés par la production concomitante de ROS. L’acétaldéhyde est ensuite transformé dans la mitochondrie en acétate, qui donnera finalement en dehors de l’hépatocyte dans d’autres organes du dioxyde de carbone (CO2). Dans ce contexte d’alcoolisation chronique, la baisse du stock intra-mitochondrial de glutathion (GSH) est démontrée dans les modèles animaux, attribuée à un défaut de transport du GSH du cytosol vers la mitochondrie (12). Ce déficit en GSH précède les lésions hépatiques chez la souris exposée à l’alcool (12). Les conséquences sont une baisse des capacités antioxydantes hépatocytaires, le GSH mitochondrial étant un mécanisme majeur de détoxification de l’excès de peroxyde d’hydrogène (H2O2) et des radicaux libres. Il a également été suggéré qu’une baisse du GSH mitochondrial pourrait rendre l’hépatocyte plus sensible au tumor necrosis factor-α (TNF-α) induisant la mort cellulaire (13).
Les processus inflammatoires
Parallèlement, la cellule de Kupffer est stimulée (14) par les lipopolysaccharides (LPS/endotoxinémie), constituant principal de la membrane externe des bacilles à Gram négatif, en provenance du tube digestif dont la perméabilité est augmentée par les épisodes répétés de consommation importante d’alcool (15). Le LPS circule avec sa protéine porteuse la LPS binding protein (LBP) et active une cascade inflammatoire induite par la voie des récepteurs Toll intracellulaire et les récepteurs TLR4 à la surface la cellule de Kupffer (16). Son activation induit la production de ROS, de cytokines pro-inflammatoires et de TNF-α. Des données suggèrent également une activation de la cellule de Kupffer par le complément C3 et C5 (17). Le TNF-α induit des lésions hépatiques par l’intermédiaire de deux récepteurs membranaires TNFR1 et TNFR2. Le récepteur TNFR1 a un rôle prédominant, comme le montre l’absence de lésion hépatique chez la souris knockout TNFR1 exposée à l’alcool (18). À l’inverse, l’activation de la cellule de Kupffer produit un effet cytoprotecteur via l’interleukine-6 (IL-6) et l’IL-10 (15). Ces deux cytokines anti-inflammatoires activent le facteur de transcription STAT3 de l’hépatocyte, des cellules endothéliales et des macrophages, à l’origine de la transcription de facteurs anti- apoptotiques, anti-oxydants et pro-oncogéniques. La régulation entre les facteurs délétères pro-inflammatoires et protecteurs anti-inflammatoires reste à éclaircir (19).
L’infiltration par des PNN autour d’hépatocytes en cours de souffrance ou de mort cellulaire est l’image histologique caractéristique de l’hépatite alcoolique (19). L’hépatite alcoolique reste une maladie multifactorielle car, à durée et quantité de consommation d’alcool égales, tous les patients ne développeront pas la maladie, suggérant un terrain de vulnérabilité génétique (20). Les données concernant les singles nucléotides polymorphismes (SNP) sont nombreuses (21), mais non concluantes (22). Les données sur l’adiponutrine (Patatin-like phospholipase domain-containing protein3, PNPLA3) semblent plus robustes. Chez des patients éthyliques chroniques, le polymorphisme rs738409 C > G est associé à un risque accru de stéatose, et de cirrhose en cas d’homozygotie G/G (23). Dans une série, la présence de l’allèle muté G était plus fréquente chez des patients ayant une hépatite alcoolique sévère par rapport à un groupe témoin sain, et était associée à une survie plus courte (24).
Figure 1 : Histologie hépatique en microscopie optique, coloration HES (Hématoxyline éosine safran).
Foyers d’hépatite alcoolique, corps de Mallory et stéatose macro vacuolaire
 |
 |
 |
A – Hépatite alcoolique avec hépatocytes
en nécrose ou apoptose entourés
de polynucléaires neutrophiles,
faible grossissement x 10 |
B – Fort grossissement x 40 |
C – Courtoisie Pr. Denis Chatelain,
Service Anatomopathologie CHU Amiens- Picardie. |
Le diagnostic Présentation clinique
Les signes cardinaux de l’hépatite alcoolique (HA) comportent habituellement un ictère récent apparu dans les 8 semaines dans un contexte de consommation excessive d’alcool de plus de 40 g/j pour les femmes et de plus de 60 g/j pour les hommes durant les 6 derniers mois. En cas d’abstinence récente, celle-ci doit être inférieure à 60 jours par rapport à l’apparition de l’ictère. Les éléments biologiques comportent une hyperbilirubinémie > 51,3 μmol/L, des transaminases AST > 50 UI/L, mais AST < 400 UI/L, avec un rapport AST/ALT >1,5 (25).
Dans la forme sévère, une insuffisance hépatique peut se traduire par une encéphalopathie, accompagnée par des signes de décompensation hépatique comme l’ascite, parfois une hémorragie par hypertension portale, voire un syndrome hépatorénal. La présentation biologique comporte alors une coagulopathie avec en général une baisse du taux de prothrombine. Une fièvre est possible, ainsi que l’hyperleucocytose à PNN. La survenue d’une hépatite alcoolique sévère doit faire systématiquement rechercher une complication infectieuse, dont la fréquence a été rapportée jusqu’à 25 %, avant tout traitement même en l’absence de sepsis évident (26). Les infections spontanées du liquide d’ascite, les pneumopathies, les infections urinaires et les dermo hypodermites sont les plus fréquentes et à rechercher systématiquement.
Le bilan complémentaire comportera une radiographie de thorax, voire un scanner thoracique sans injection, une ponction d’ascite, un examen cytobactériologique des urines et des hémocultures en cas de fièvre. L’examen hépatique par une échographie est d’usage pour le bilan de l’hépatopathie, mais aussi pour le diagnostic différentiel de syndrome cholestatique comme l’angiocholite. Enfin une autre maladie hépatique virale C ou B mais aussi A ou E associées doivent aussi être écartées par des tests sérologiques.
Pour conclure sur le diagnostic, il est désormais recommandé d’éviter les termes « hépatite alcoolique aiguë sévère (HAA) ou non sévère », et d’utiliser les dénominations « hépatite alcoolique symptomatique » en cas d’ictère, en distinguant la forme sévère de la forme modérée, au lieu de forme non-sévère.
Biopsie hépatique et arguments histologiques
La place de la confirmation histologique a été précisée par un groupe d’experts sur l’hépatite alcoolique rassemblé par le NIAAA, dans 3 groupes de patients (figure 2) (25).
- Le groupe avec une hépatite alcoolique confirmée par une biopsie hépatique, correspondant aux patients inclus dans les essais cliniques, en général les formes sévères semblables à celles rencontrées en soins courants.
- Le groupe avec une hépatite alcoolique probable présentant les signes cliniques habituels sans autres causes évidentes (Ac anti nucléaire < 1/150, Ac anti muscle lisse < 1/80, pas de contexte métabolique, pas de sepsis, ni de choc vasculaire, ni hépatite médicamenteuse ou usage de cocaïne, et sans virus des hépatites), pour laquelle la biopsie hépatique n’est pas utile car le risque de faux positif est < 10 %.
- Enfin le groupe avec une hépatite alcoolique possible ou la biopsie est recommandée car comportant de nombreux facteurs confondants (doute sur le mésusage d’alcool, choc vasculaire hémorragique, usage de cocaïne < 7 jours, hépatite médicamenteuse possible), ou avec une présentation biologique atypique avec AST < 50 UI/L, AST/ALT < 1,5, AST > 400 UI/L, ou bilirubine < 51,3 μmol/L.
Pour la forme sévère d’hépatite alcoolique symptomatique la biopsie hépatique est souhaitable (1,27,28), car dans 20 à 30 % des cas, les signes d’hépatite alcoolique ne sont pas trouvés sur la biopsie hépatique de patients avec un score de Maddrey ≥ 32 (29,30). La ponction biopsie hépatique sera réalisée le plus souvent par voie transjugulaire, en raison des anomalies de la coagulation ou de la présence d’ascite. La décision de pratiquer la biopsie hépatique doit aussi tenir compte des disponibilités techniques locales. Sa réalisation, parfois différée, ne doit pas retarder l’instauration du traitement dans les formes sévères. Dans deux études observationnelles, seuls 1/3 des patients avaient réellement une biopsie hépatique transjugulaire (31,32). Les informations apportées par l’histologie sont d’ordre diagnostique, avec la présence d’une ballonisation hépatocytaire, des corps de Mallory et une infiltration de PNN autour d’hépatocytes en voie de nécrose ou d’apoptose (33). L’histologie précise également la présence et l’extension de la fibrose, la plupart du temps au stade de cirrhose. Des informations d’ordres pronostiques sont également apportées par l’étude histologique (34).
Enfin des alternatives non-invasives à la biopsie hépatique ont été étudiées, comme l’AshTest®, le dosage sérique de la laminine (35,36), ou encore l’apport de marqueurs de nécrose cellulaire comme la cytokeratin 18 (37,38), mais ces tests manquent encore de validations indépendantes.

1recommandation grade A1; 2recommandation grade B2 (Guidelines EASL 2018 [1], et AASLD 2019 [27])
Évaluer le pronostic
La fonction discriminante de Maddrey (DF), appelée score de Maddrey, permet de d’identifier les patients ayant une hépatite alcoolique sévère. Publiée initialement en 1978 (39), et modifiée par Carithers et al. en 1989 (40), elle est calculée selon la formule : [TP(sec)patient – TP(sec)témoin] x 4,6 + bilirubine totale (μM)/17. Dans une analyse rétrospective réalisée sur les groupes placebo de trois essais randomisés, le groupe des patients avec une DF supérieure ou égale à 32 avait une survie spontanée à 28 jours significativement plus basse de 67,6 ± 7,1 % versus 93,2 ± 3,8 % pour les malades avec une DF inférieure à 32 (p = 0,003) (3). Le score de Maddrey est le plus validé dans les études et le plus utilisé comme critère d’inclusion dans les essais cliniques. Il est simple et facile à utiliser au lit du malade (table 1).
D’autres scores plus récents, issus d’analyses multivariées, ont été investigués. Le score de MELD (Model for End-stage Liver Disease) décrit initialement pour évaluer le pronostic des patients cirrhotiques avec une hypertension portale a été évalué chez des patients avec une hépatite alcoolique (44-41). Dans ces études, le MELD était associé à la mortalité des patients évaluée à J30 ou à J90, avec des aires sous la courbe ROC (Receiver Operating Characteristic) comprises entre 0,76 à 0,97. Cependant, les cut-offs décrits étaient variables entre 18 à 25 pour définir la forme sévère d’hépatite alcoolique, et sans différence statistique avec la DF de Maddrey. Pour estimer la survie à J30, le cut-off serait entre 18 à 22 avec des sensibilités et spécificités entre 75 %-85 % et 75 %-84 % (44-41).
Le Glasgow Alcoholic Hepatitis Score (GAHS) comporte cinq variables indépendamment associées à la mortalité (âge, globules blancs, temps de prothrombine, bilirubine), auxquelles des points croissants (1 à 3 points) sont alloués selon la gravité. Avec GAHS ≥ 9, la survie était significativement inférieure à J28 et J84 par rapport au groupe ayant un GAHS < 9, avec une sensibilité à 54 %, spécificité à 89 % et accuracy à 81 % (45). La même équipe a ensuite testé l’impact d’un traitement par corticostéroïdes selon le GAHS. Les patients avec un GAHS ≥ 9 avaient une meilleure survie lorsqu’ils étaient traités par corticostéroïdes par rapport à ceux traités par placebo, alors que les corticostéroïdes n’amélioraient pas la survie chez les patients avec un GAHS < 9 par rapport au placebo (46).
Le score ABIC [(âge*0,1) + (bilirubine*0,08) + (INR*0,8) + (Créatinine*0,3)] définissait trois sous-groupes de patients avec une HA de pronostic différents (47) : avec un score < 6,71 la survie était de 100 % à J90, alors qu’avec un score > 9 la survie n’était que de 25 % (sensibilité 70 %, spécificité 33 %, AUROC 0,82). Le groupe intermédiaire, avec un score compris entre 6,71 à 9, avait une survie à 70 % (p < 0,0001). L’aire sous la courbe ROC était significativement supérieure à celle de la DF de Maddrey dans la population de construction du modèle, mais le score ABIC était comparable aux scores MELD et GAHS dans la population de validation. De plus, dans une série indépendante, les patients, avec le meilleur pronostic avec un score ABIC < 6,71, avaient finalement une mortalité de 17,8 % à 84 jours (48).
Récemment le concept d’Acute-on-Chronic Liver Failure (ACLF) a été développé dans l’étude CANONIC par le consortium européen EASL- CLIF (Chronic LIver Failure) pour mieux définir le pronostic des maladies chroniques du foie (49,50). Une première étude décrit l’incidence d’une ACLF chez 165 patients avec une hépatite alcoolique sévère dont 85 % étaient traités par corticostéroïdes (51). Au diagnostic de l’HAA, 47,9 % des patients avaient une ACLF, avec un impact sur la survie (15,7 % étaient ACLF 1, mortalité 30,8 % à J28 ; 14,5 % étaient ACLF 2, mortalité 58,3 % à J28 ; et 17,6 % étaient ACLF 3, mortalité 72,4 % à J28, p < 0,0001), ainsi qu’une moins bonne réponse aux corticostéroïdes (38,2 vs. 76,6 %, p < 0,0001). Cependant la valeur prédictive de la survie à J28 des patients avec une HAA était comparable entre la fonction dérivée de l’ACLF (https://www.clifresearch.com/ToolsCalculators.aspx) et le score de Maddrey avec un C index respectif de 0,68 (IC95 % : 0,59-0,76) et 0,64 (IC95 % :
0,56-0,73). Parmi les patients sans ACLF au diagnostic, 33 % développaient une ACLF au cours du suivi de 168 jours. Au total 65,5 % des patients ayant une HAA ont ou développeront une ACLF. Le seul facteur prédictif indépendant en analyse multivariée de développer une ACLF de novo était l’infection au cours du suivi. Le développement d’une ACLF chez les patients avec une HAA est donc fréquent, mais la place de la fonction dérivée reste à déterminer.
Au total, parmi tous les scores pronostiques définissant l’hépatite alcoolique sévère, la DF de Maddrey et le GASH sont validés pour le pronostic et l’indication du traitement, alors que le MELD et ABIC sont pronostiques sans avoir réellement démontré l’intérêt thérapeutique. GASH et ABIC restent peu validés par des études indépendantes. Les recommandations des sociétés européenne EASL 2018 (1) et américaine AASLD 2019 (27) ont indiqué l’usage du score de Maddrey ≥ 32 ou du MELD > 20 en première intention, en cas de présomption d’hépatite alcoolique pour estimer le pronostic sévère. A contrario, en cas de score de Maddrey < 32 le traitement n’est que symptomatique, tout en soulignant qu’il faille abandonner le terme de « non sévère » pour une désignation plus précise d’hépatite alcoolique symptomatique modérée comportant une mortalité de presque 10 % à 6 mois et de 20 % à un an (27).
Tableau 1 : Performances des scores pronostiques de l’hépatite alcoolique
|
Prédiction survie |
Cut off |
Sensibilité (%) |
Spécificité (%) |
VPP (%) |
VPN (%) |
AUROC |
| Maddrey [39,40,43] |
J28 |
≥ 32 |
83 % |
60 % |
29 % |
88 % |
0,81 |
| MELD [42] |
J30 |
≥ 18 |
85 % |
84 % |
47 % |
97 % |
0,89 |
| MELD [43] |
J30 |
≥ 22 |
75 % |
75 % |
– |
– |
0,83 |
| GAHS [45] |
J28 |
≥ 9 |
54 % |
89 % |
61 % |
86 % |
0,81* |
| ABIC [47] |
J90 |
≥ 9 |
70 % |
33 % |
– |
– |
0,82 |
*Accuracy ; Maddrey : (TPpatient (sec) -TPtémoins) + Bilirubine/17 ; MELD : Model for End Stage of Liver Disease ; ABIC : Age Bilirubin INR Creatinin ; GASH : Glasgow Alcoholic Hepatitis Score
Les traitements
Le traitement des patients souffrant d’une hépatite alcoolique symptomatique sévère nécessite une admission dans un service à orientation hépatologique pour confirmer le diagnostic et sa sévérité, entreprendre le traitement médicamenteux, mettre en place le soutien nutritionnel et addictologique dans le but de limiter la morbi-mortalité à court terme. Les patients les plus graves nécessitent des mesures réanimatoires sans délai. À long terme la stratégie de prise en charge passe par un suivi hépatologique mais aussi addictologique en vue d’obtenir une abstinence soutenue et prolongée.
La prise en charge addictologique
La prise en charge addictologique est communément admise comme étant essentielle dans l’hépatite alcoolique (1), cependant peu d’études se sont intéressées à l’évaluer tant elle est implicitement recommandée alors que dans les faits, compte tenu du pronostic vital dans la forme sévère, la part somatique éclipse souvent la part addictologique dans les premières semaines de la prise en charge médicale. Ainsi, les traitements addictologiques de référence (acamprosate et naltrexone) n’ont pas bénéficié d’évaluation dans l’hépatite alcoolique symptomatique sévère, même si le baclofène a été testé dans une étude randomisée en double aveugle contrôlée versus placebo chez 84 patients cirrhotiques, dont 66 % étaient au stade C du score de Child-Pugh avec des niveaux maximum de bilirubine à 56 μmol/l et un INR à 52) 2,7). Le groupe traité par baclofène pendant 12 semaines avait 71 % de patients abstinents versus 29 % dans le groupe placebo (OR = 6,3 [IC95 % : 2,4–16,1], p = 0,0001), avec une bonne tolérance. Il n’y a pas à ce jour de données chez des patients cirrhotiques Child-Pugh C avec une hépatite alcoolique symptomatique sévère.
La prise en charge nutritionnelle
La supplémentation nutritionnelle est un point essentiel de la stratégie globale de prise charge de l’hépatite alcoolique symptomatique sévère. L’apport calorique de l’alcool et les volumes ingérés, sont anorexigènes induisant fréquemment une dénutrition. De plus l’alimentation per os est souvent altérée avec un taux de survie plus faible pour les patients consommant moins de 21,5 kcal/kg/jour (53). Les corrections nutritionnelles nécessaires doivent atteindre 1,2 à 1,5 g de protéines/kg/j et 35-40 kcal/kg/j (54). La voie orale doit être privilégiée, mais l’utilisation d’une nutrition entérale par sonde naso jéjunale est possible, mais souvent mal tolérée. La nutrition entérale pourrait participer à une diminution de l’endotoxémie (55).
En dépit du rationnel concernant le support nutritionnel chez les patients ayant une HA symptomatique sévère, son impact sur la survie n’est pas bien démontré. L’étude de Cabre et al. n’avait pas montré de différence de survie à J28 avec la nutrition entérale versus les corticostéroïdes, mais la nutrition entérale réduisait la mortalité à long terme, le croisement des courbes de survie appelant à une interprétation prudente (55). Une étude plus récente montre que la combinaison d’une nutrition entérale intensive par sonde naso-gastrique avec des corticostéroïdes n’était pas plus efficace que celle des corticostéroïdes seuls (56). Dans une analyse de sous-groupe, les patients avec une HA symptomatique sévère ayant reçu moins de 21,5 kcal/kg/j avaient une mortalité et une fréquence d’infection plus importantes à 1 mois et à 6 mois (56).
Bien qu’il n’y ait pas de bénéfice de survie démontré, la mise en place d’un soutien nutritionnel pour les patients ayant une hépatite alcoolique symptomatique sévère est recommandée (1,27).
Les traitements médicamenteux
Corticostéroïdes
Les corticostéroïdes ont été testés dans 15 essais cliniques et 9 méta-analyses (65-57). Dans 2 méta-analyses, les auteurs concluaient à une inefficacité des corticostéroïdes (60,62), mais dans l’une, l’analyse de sensibilité dans le sous-groupe de patients avec un score de Maddrey ≥ 32, la survie était améliorée par rapport à celle du groupe placebo (62). Dans 2 méta-analyses à données individuelles (61,63), la survie à court terme à J28 était améliorée par les corticostéroïdes versus le placebo (79,9 ± 2,8 vs. 65,7 ± 3,4 %, p = 0,005). Les données de survie à moyen terme sont moins nombreuses et montraient dans une analyse poolée de 2 essais une meilleure survie dans le groupe corticostéroïdes à 2 mois (75 ± 5 vs. 56 ± 6 %, p = 0,01) et à 6 mois (67 ± 5 vs. 43 ± 6 %, p < 0,01) (61). Récemment dans le plus grand essai randomisé en double aveugle ayant inclus 1 106 patients (étude STOPAH), la survie à J28 était améliorée par les corticostéroïdes [HR = 0,72 (IC95 % : 0,52-1,01) ; p = 0,06], la différence devenant significative qu’après ajustement sur les facteurs pronostiques indépendants [HR = 0,61 (IC95 % : 0.41-0,91) ; p = 0,02] (66). Par contre, il n’y avait aucun bénéfice de survie à 3 mois, ni à 1 an (66). Cette étude a été incorporée dans une nouvelle méta analyse à données individuelles, incluant 11 études et 2 111 patients (65). Les résultats indiquent une meilleure survie à J28 avec les corticostéroïdes [HR = 0,64 (IC95 % : 0.48- 0,86) ; p = 0,003], avec un gain de survie de 7,8 % avec les corticostéroïdes (IC95 % : 2,6 – 12,6 %), NNT = 13). À 6 mois, il n’y avait pas de bénéfice de survie (65). Enfin dans une étude rétrospective multicentrique non randomisée portant sur 3 380 patients avec HA symptomatique sévère (diagnostic clinique ou histologie), les corticostéroïdes réduisaient la mortalité à J30 de 41 % (HR 0,59, IC95 % : 0,47-0,74, p < 0,001) après analyse incluant de multiples ajustements, mais pas à J90 ni à J180 (67). En tenant compte de l’intervalle de confiance, un gain de survie maximum lié aux corticostéroïdes de 21 à 30 % était observé pour un score de MELD entre 25 et 39. Il n’y avait aucun gain de survie pour un score de MELD en dessous de 21 et au-dessus de 51 (67). Ainsi l’ensemble des données sont en faveur d’un gain de survie à J28, mais pas d’effet à moyen et long terme. Les corticostéroïdes sont donc recommandés en traitement de première ligne avec un grade A1 selon les guidelines européennes EASL 2018 et américaines AASLD 2019 (1,27), à la dose de 40 mg/j de prednisolone ou 32 mg/j de methylprednisolone pendant 28 jours, suivi d’un arrêt soit progressif, soit sans décroissance.
Corticostéroïdes plus N-acétylcystéine (bi-thérapie)
L’utilisation d’un traitement antioxydant serait justifiée par la présence du stress oxydatif dans l’hépatite alcoolique. La N-acétylcystéine (NAC), par sa capacité à restaurer le niveau de glutathion cellulaire et son action anti-oxydante, a été testée dans le traitement de l’hépatite alcoolique symptomatique sévère, seule ou en combinaison. En monothérapie, un essai randomisé a été arrêté à l’analyse intermédiaire car l’utilisation d’un cocktail d’antioxydants (comportant la N-acétylcystéine) donné pendant 28 jours à la fois par voie orale et en perfusion était significativement inférieure à la prednisolone à 30 mg/j pour la survie à un mois (68). Dans une autre étude, la N-acétylcystéine en perfusion pendant 14 jours plus une nutrition orale et entérale était comparée à la nutrition orale et entérale seule. Il n’y avait aucune différence de survie à 6 mois (69). Ces 2 essais suggèrent que la stratégie anti-oxydante seule sans corticostéroïdes n’est pas efficace pour traiter l’hépatite alcoolique sévère. Combiner une stratégie anti-oxydante avec une stratégie anti-inflammatoire aurait l’avantage d’agir à la fois sur les deux phénomènes physiopathologiques, le stress oxydatif et l’excès de TNF-α. Dans un essai randomisé, la perfusion de N-acétylcystéine pendant une semaine avec un cocktail anti-oxydant par voie orale pendant six mois plus corticostéroïdes n’améliorait pas la survie par rapport au groupe placebo plus corticostéroïdes (70), mais cette étude comportait des biais et un manque important de puissance (71). Dans une autre étude multi-centrique française, 174 patients ayant une hépatite alcoolique sévère ont été randomisés entre une combinaison de N-acétylcystéine perfusée pendant 5 jours plus 40 mg de prednisolone par voie orale pendant un mois versus une perfusion de cinq jours de glucosé 5 % plus prednisolone pendant un mois (72). Dans le groupe des patients traités par la combinaison thérapeutique, la mortalité était significativement moins importante à 1 mois (8 % versus 24 %) (HR = 0,58 [IC95 % : 0,14-0,76], p = 0,006), à 2 mois (15,3 % vs. 32,6 %, p = 0,007, analyse post hoc), mais pas à six mois (22,4 vs. 33,7 %) [HR=0,62 IC95 % : 0,37-1,06], p = 0,07) qui était l’objectif principal. Le nombre de décès par syndrome hépatorénal était significativement plus faible dans le groupe N-acétylcystéine + corticostéroïdes versus dans le groupe corticostéroïdes seuls (9 % versus 22 %) [OR = 2,79, (IC95 % : 1,08–7,42), p = 0,02]. Ces résultats étaient en faveur d’un gain de survie précoce avec cette nouvelle stratégie thérapeutique « Corticostéroïdes-NAC », qui a reçu une recommandation européenne EASL 2018 comme traitement de première ligne possible dans l’hépatite alcoolique sévère avec un grade B2 (1), ainsi que par l’AASLD 2019 (27). La NAC associée aux corticostéroïdes est perfusée les 5 premiers jours à la dose de 150 mg/kg dans 250 ml de glucosé 5 % en 30 à 45 minutes, puis 50 mg/kg dans 500 ml de G5 % en 4 heures, puis 100 mg/kg en 16 heures, la troisième dose étant renouvelée du J2 au J5, puis les corticostéroïdes poursuivis seuls jusqu’à J28 (72).
Autres traitements non démontrés
Parmi les autres traitements, la pentoxifylline est un inhibiteur de la phosphodiestérase et de la synthèse du TNF-α. Son utilisation dans l’hépatite alcoolique aiguë sévère résultait de l’amélioration de la survie intra hospitalière dans un essai randomisé en double aveugle, avec moins de syndrome hépatorénal (73). Cependant les 6 essais suivants n’ont pas permis de démontrer une supériorité de la pentoxifylline dans l’hépatite alcoolique sévère, que ce soit seule ou associée aux corticostéroïdes versus placebo ou versus corticostéroïdes (79-74). Trois méta-analyses ont testé la pentoxifylline. Le groupe Cochrane avait rapporté pour 5 études, une amélioration de la survie et moins de syndrome hépatorénal, mais en analyse avec ajustements (trial sequencing testing), il n’y avait plus de différence (80). Dans la deuxième méta-analyse, la pentoxifylline a été jugée efficace dans une méta- analyse en réseau, mais pas en méta-analyse classique (64). Enfin dans la troisième méta-analyse avec données individuelles, aucun bénéfice de survie n’a été démontré pour la pentoxifylline quel que soit son mode d’utilisation, seule ou associée aux corticostéroïdes (65). Avec l’ensemble de ces données, la pentoxifylline n’est plus recommandée selon les guidelines de l’EASL 2018 (1) et de l’AASLD 2019 (27).
Une approche thérapeutique séduisante a essayé de répondre aux mécanismes physiopathologiques liés aux bactériémies. L’association d’une antibiothérapie aux corticostéroïdes diminuait significativement l’incidence des infections, mais n’a pas eu de bénéfice de survie à 2 mois versus les corticostéroïdes seuls dans un essai randomisé en double aveugle (81).
Du fait de la constatation de taux élevés de TNF-α dans les modèles animaux et chez les patients avec une HAA sévère, des stratégies de traitement anti-TNF-α ont fait l’objet d’essais cliniques. Malheureusement l’essai testant un anti TFN-α (infliximab) plus corticostéroïdes versus corticostéroïdes seuls avait été arrêté précocement devant un surcroit d’infections sévères dans le groupe avec l’anti-TNF-α (82). Par ailleurs l’association d’un anti récepteur soluble du TNF-α (etanercept) en sous cutané versus placebo avait montré une surmortalité dans le groupe anti- TNF-α avec un surcroît également significatif d’infections sévères (83). Ainsi les anti-TNF-α seuls ou associés aux corticostéroïdes ne sont pas indiqués dans l’HA symptomatique sévère (65).
Une autre stratégie cible la régénération hépatique qui paraît défaillante dans l’HA symptomatique sévère (84). Dans une étude pilote randomisée, l’injection de facteurs de croissance des granulocytes (G-CSF) induisait significativement une augmentation de cellule souches (CD34+) sanguine et de l’Hepatocyte Grow Factor (HGF) sanguine et intra hépatique (85). Un essai randomisé ouvert indien portant sur 46 patients avec une hépatite alcoolique symptomatique sévère, a comparé la combinaison G-CSF plus pentoxifylline versus pentoxifylline seule, montrant une augmentation des CD34+ (p = 0,019) et une meilleure survie à J90 dans le groupe avec le G-CSF en sous-cutané pendant 5 jours (78,3 % vs. 30,4 %, p = 0,001) (86). Un autre essai avec 57 patients avec une HA symptomatique sévère, provenant du même groupe a montré les mêmes résultats du G-CSF plus pentoxifylline versus la pentoxifylline (87). L’efficacité de la pentoxifylline dans l’HA symptomatique sévère est aujourd’hui remise en question, de sorte que lorsque la comparaison a été faite dans une autre étude randomisée avec l’association G-CSF plus transplantation autologue intra artérielle hépatique de cellules souches plus corticostéroïdes versus corticostéroïdes seuls, l’effet du G-CSF n’a pas été démontré, sans gain de survie à 3 mois, pas de différence sur la fonction hépatique et pas de modification des cellules souches intra hépatique sur la biopsie hépatique à 3 mois (88). Ainsi l’utilisation du G-CSF dans l’HA symptomatique sévère n’est pas indiqué en soins courants (1,27).
Des données préliminaires sur la transplantation de microbiote intestinal rapportent une meilleure survie à J28 des patients avec une hépatite alcoolique symptomatique sévère non éligibles aux corticostéroïdes versus un groupe de patients historiques avec une HA symptomatique sévère, mais l’essai était non randomisé, avec une mortalité du groupe témoins inhabituelle (89). Le concept de la transplantation de microbiote intestinal dans l’HA symptomatique sévère reste à démontrer.
Épurations extra hépatiques
La dialyse extra corporelle sur colonne d’albumine (Système MARS : Molecular Adsorbent Recirculating System) avait donné des résultats préliminaires encourageants dans de petites séries de patients avec une hépatite alcoolique symptomatique sévère, induisant une diminution de l’hypertension portale chez 9 patients traités (90), une amélioration biologique (baisse de la bilirubine et de la créatinine sérique) et une diminution de l’encéphalopathie hépatique sur 8 autres patients (91). Cependant, dans une série de 19 patients avec une HA symptomatique sévère traités par le système MARS versus 19 patients témoins appariés et traités par corticostéroïdes, il n’y avait pas de différence de survie à 1 et à 2 mois (92).
Dans l’étude internationale RELIEF, 189 patients avec une ACLF ont été randomisés pour recevoir un traitement par le système MARS versus un traitement standard. Plus de 81 % des patients avaient une consommation d’alcool excessive, mais cependant il n’y avait pas de biopsie hépatique. Des patients avaient potentiellement une hépatite alcoolique non diagnostiquée histologiquement. L’essai n’avait pas démontré de différence de survie avec le système MARS dans la globalité, ni dans des sous-groupes de patients avec une encéphalopathie hépatique, un score de MELD > 20 ou avec une hyperbilirubinémie progressive (93). Ces données montrent l’absence probable d’efficacité de la dialyse sur colonne d’albumine avec le système MARS dans le traitement de l’hépatite alcoolique symptomatique sévère.
Un autre système d’épuration hépatique extra corporelle par des cellules C3A dérivant de lignées d’hépatoblastome (ELAD : Extracorporeal Cellular Therapy) a été étudié dans une étude randomisée contrôlée internationale (94). Deux cent trois patients avec une HA symptomatique sévère étaient randomisés pour recevoir soit un traitement standard (SOC) plus ELAD pendant 72 à 120 heures (n = 96), soit un traitement standard seul (n = 107). Il n’y avait pas de différence de survie à J28 (76 % vs. 80,4 %) et à J90 (59,4 vs. 61,7 %) entre les groupes SOC plus ELAD et SOC respectivement. Les effets secondaires graves étaient comparables entre les 2 groupes. Les résultats de mortalité étaient également non significatifs dans les sous-groupes pré spécifiés MELD > 28 (68,9 vs. 55,3 %, p = 0,15) ou âge > 46,9 ans (60,4 vs. 51 %, p = 0,26). Il y avait une tendance mais non significative à moins de mortalité dans le groupe ELAD pour MELD < 28 (29,4 vs. 43,5, p = 0,08) ou âge < 46,9 ans (32,6 vs. 44,8 %, p = 0,17). Dans une analyse post hoc, le sous-groupe avec les meilleurs critères MELD < 28 et âge < 46,9 ans avait un bénéfice du traitement par ELAD avec une survie de 100 % vs. 75 %, p = 0,006. Il faut noter que les patients étaient traités dans moins de 50 % des cas par corticostéroïdes qui est normalement le SOC. Il n’y a pas eu d’analyse excluant les patients non traités par corticostéroïdes. Globalement l’étude est négative et l’association ELAD plus SOC n’apportant pas de bénéfice évident de survie, ne peut être recommandée dans le traitement des patients avec une HA symptomatique sévère.
La réponse au traitement
Dans une étude rétrospective, la baisse précoce de la bilirubine au septième jour de traitement, définie par une valeur absolue à J7 numériquement inférieure à celle du J0, était associée à une survie de 3,3 ± 82,8 % à six mois versus 23 ± 5,8 % en l’absence de baisse (95). La baisse précoce de la bilirubine au septième jour était dans cette étude un facteur pronostique indépendant de la survie à six mois. Dans une autre étude, les facteurs associés à la survie au sixième mois ont été analysés chez 295 patients avec une HAA sévère (96). Six variables indépendantes, l’âge, l’albuminémie, la bilirubine à J0 et à J7, l’insuffisance rénale, et le taux de prothrombine, étaient incorporées dans un score nommé modèle de Lille (http://www.lillemodel.com/score.asp). Avec un cut-off à 0,45, le modèle de Lille permettait de prédire la survie au sixième mois avec une sensibilité de 76 % et une spécificité de 85 %. En utilisant la baisse précoce de la bilirubine à J7, ou le modèle de Lille ≤ 0,45, 73,2 % et 62 % des patients respectivement pouvaient être classés comme étant répondeurs au traitement, avec la meilleure survie prévisible. A contrario, les patients non répondeurs étaient définis par l’absence de baisse de la bilirubine à J7 ou par un modèle de Lille > 0,45. Chez ces patients, la survie à six mois était plus faible, mais intéressait tout de même 23 ± 5,8 % à 25 ± 96) % 3,8). Seuls les patients avec un modèle de Lille supérieur à 0,56 ne tiraient aucun bénéfice du traitement par corticostéroïdes par rapport aux mêmes patients non traités par corticostéroïdes. Un modèle de Lille supérieur à 0,56, correspondant à la réponse nulle, pourrait représenter le cut-off décisionnel pour envisager l’arrêt des corticostéroïdes au septième jour (63). La prédiction pronostique pourrait être plus robuste en combinant 2 méthodes (97). Ainsi la combinaison d’un score statique le MELD, avec un score dynamique le modèle de Lille, améliore la prédiction de la mortalité des patients non répondeurs aux corticostéroïdes, en comparaison avec le MELD ou le modèle de Lille seuls. Par ailleurs cette combinaison était supérieure à toutes les autres (Maddrey-Lille ; Child Pugh-Lille).
Traitements de seconde ligne
En cas de non réponse aux corticostéroïdes, la mortalité spontanée à 6 mois est dramatiquement élevée à 75 % (96). Une étude franco-belge avait réalisé une transplantation hépatique précoce pour 26 patients non répondeurs aux corticostéroïdes avec un score médian de Lille à 0,88 (98).
La survie était significativement meilleure avec 77 ± 8 % de patients vivants au 6e mois dans le groupe transplantation hépatique précoce, en comparaison avec seulement 23 ± 8 % dans le groupe témoins historiques appariés et également non répondeurs aux corticostéroïdes (p < 0,001). La différence était maintenue à 2 ans (71 ± 9 vs. 23 ± 8 %, p < 0,001), et le taux de rechute d’alcoolisation était de 11,5 % à 2 ans. Du fait de l’impossibilité d’appliquer la règle usuelle de l’abstinence alcoolique de 6 mois pour une transplantation hépatique précoce, les patients avec une HA symptomatique sévère résistante aux corticostéroïdes étaient rigoureusement sélectionnés. Il s’agissait de patients en primo épisode d’HA symptomatique sévère, non répondeurs aux corticostéroïdes évalués par le modèle de Lille > 0,45 à J7, possédant un entourage familial aidant, s’engageant à une abstinence durable, sans co-morbidité sévère, ni de maladie psychiatrique, et ayant donné leur accord. Le processus de décision devait être consensuel entre 4 équipes : 1 infirmière, 1 étudiant et 1 interne en médecine constituaient le premier cercle, le médecin addictologue représentait le deuxième cercle, l’hépatologue senior représentait le troisième cercle, et le médecin anesthésiste et le chirurgien transplanteur représentaient le quatrième cercle. Cette étude a changé l’acceptabilité de la transplantation hépatique précoce pour les patients avec HA symptomatique sévère non répondeurs parmi les membres des équipes de transplantation (99). Néanmoins, le mode de sélection fait l’objet d’étude de validation en cours, l’accès à un nombre de greffon hépatique limité faisant entrer en « compétition » d’autres maladies graves du foie non liées à l’alcool ainsi que les cancers du foie. Depuis cette étude, d’autres séries ont été publiées (100), avec des résultats comparables. Dans la cohorte du consortium américain pour la transplantation hépatique précoce des patients avec une hépatite alcoolique symptomatique sévère résistante aux corticostéroïdes avec une médiane du modèle de Lille à 0,82, la survie était à 94 % à 1 an et 84 % à 3 ans (101). La question de la rechute de la consommation d’alcool post transplantation est cruciale, et a été estimée à 25 % à 1 an et à 34 % à 3 ans si on prend une définition large « quelle que soit la re-consommation », et à 11 % à 1 an et 17 % à 3 ans si on retient une « consommation régulière et soutenue » (102). La non-infériorité de la rechute de la consommation d’alcool à 2 ans après transplantation hépatique précoce pour HA symptomatique sévère (33,8 %) n’a pu être démontrée par rapport aux patients greffés pour cirrhose alcoolique ayant respecté la règle d’abstinence de 6 mois (24,7 %), et la re-consommation excessive était même supérieure dans le groupe transplanté précocement pour hépatite alcoolique symptomatique sévère corticorésistante (22,1 % vs. 5,4 %,
p < 0,01) (103). Une méta-analyse confirme l’ensemble des résultats de survie à 80 % à 6 mois avec un taux de rechute de consommation d’alcool à 14 % (104). Ces taux de rechutes soulignent et renforcent la nécessité de la prise en charge addictologique conjointe.
Les infections dans l’hépatite alcoolique
Les infections sont fréquentes chez les patients avec une hépatite alcoolique symptomatique sévère. Une étude rapporte 25,6 % d’infections constatées dès l’admission à l’hôpital, avant tout traitement (dont 44,4 % d’infections du liquide d’ascite, 12,7 % de pneumopathies, 31,7 % d’infections urinaires et 11,2 % d’autres sites) (26). Une méta-analyse rapporte 18,7 % d’infections dans un groupe de patients avec hépatite alcoolique symptomatique sévère non traitée (105). L’infection, si elle est contrôlée par antibiotique, ne contre indique pas formellement les corticostéroïdes. La survie à 2 mois était comparable chez les patients infectés et contrôlés par antibiotiques puis traités secondairement par corticostéroïdes par comparaison aux patients non infectés et traités d’emblée par corticostéroïdes (70,9 % vs. 71,6 %, p = 0,99) dans une étude (26). Une question rémanente est la crainte du risque d’infection pendant le traitement par corticostéroïdes. Dans l’essai STOPAH les infections survenaient dans 13 % des cas dans le groupe ayant reçu les corticostéroïdes contre 7 % parmi les patients sans corticostéroïdes (p = 0,002) (66). Une méta analyse n’a pas montré de différence d’incidence d’infection bactérienne avec ou sans corticostéroïdes (OR = 0,98, IC95 % : 0,49-1,94) (105). Dans une autre étude, les infections survenaient dans 23,7 % des patients traités par corticostéroïdes (dont 28,1 % d’infections d’ascite, 40,3 % de pneumopathies, 17,5 % d’infections urinaires, et 14,1 % d’autres sites) (26), mais plus que la responsabilité directe des corticostéroïdes, la réponse au traitement avec un modèle de Lille ≤ 0,45 était un élément clef avec moins d’infection par rapport aux patients non répondeurs (11,1 % vs. 42,5 %, p < 0,000001) (26). Enfin des infections fungiques ou des pneumocystoses sont également possibles, de diagnostic difficile et survenant chez des patients avec un MELD élevé (106). Le recours à la TDM thoracique doit être un réflexe chez ces patients graves.
Conclusions
L’hépatite alcoolique symptomatique sévère doit être reconnue par un score de Maddrey ≥ 32, et au mieux confirmée par une histologie hépatique obtenue par voie trans-jugulaire. Les infections bactériennes, très fréquentes dans ce contexte, doivent être dépistées systématiquement avant le traitement. Les corticostéroïdes représentent le traitement de première ligne, associés à un soutien nutritionnel adapté et à une abstinence alcoolique. L’association corticostéroïdes plus N-acétylcystéine améliore la survie à court terme par rapport aux corticostéroïdes seuls, constituant une option thérapeutique de première ligne. La réponse au traitement est évaluée au septième jour par la baisse du modèle de Lille < 0,45. Chez les patients non répondeurs aux corticostéroïdes, la transplantation hépatique précoce, chez des patients sélectionnés, améliore la survie significativement.
Bibiliographie
- EASL Clinical Practice Guidelines: Management of alcohol-related liver disease. European Association for the Study of the Liver. J Hepatol 2018 Apr 5. pii: S0168-8278(18)30214-9.
- Gao B, Bataller R. Alcoholic liver disease: pathogenesis and new therapeutic targets. Gastroenterology. 2011 Nov;141(5):1572-85.
- Mathurin P, Mendenhall CL, Carithers Jr RL, et al. Corticosteroids improve short-term survival in patients with severe alcoholic hepatitis (AH): individual data analysis of the last three randomized placebo controlled double blind trials of corticosteroids in severe AH. J Hepatol 2002;36:480–7.
- Mathurin P, O’Grady J, Carithers RL, et al. Corticosteroids improve short-term survival in patients with severe alcoholic hepatitis: meta-analysis of individual patient data. Gut 2011;60:255–60.
- Yan AW, Fouts DE, Brandl J, et al. Enteric dysbiosis associated with a mouse model of alcoholic liver disease. Hepatology 2011 ;53:96–105.
- Ciocan D, Rebours V, Voican CS, et al. Characterization of intestinal microbiota in alcoholic patients with and without alcoholic hepatitis or chronic alcoholic pancreatitis. Sci Rep 2018 Mar 19;8(1):4822. doi: 10.1038/s41598-018-23146-3.
- Grewal RK, Mahmood A. Ethanol induced changes in glycosylation of mucins in rat intestine. Ann Gastroenterol 2009 ;22:178–183.
- Ulluwishewa D, Anderson RC, McNabb WC, et al. Regulation of tight junction permeability by intestinal bacteria and dietary components. J Nutr 2011 ;141:769–776.
- Llopis M, Cassard AM, Wrzosek L, et al. Intestinal microbiota contributes to individual susceptibility to alcoholic liver disease. Gut 2016 May;65(5):830-9.
- Albano E, Clot P, Morimoto M, et al. Role of cytochromeP4502E1-dependent formation of hydroxyethyl free radical in the development of liver damage in rats intragastrically fed with ethanol. Hepatology 1996;23:155–63.
- Hirano T, Kaplowitz N, Tsukamoto H, et al. Hepatic mitochondrial glutathione depletion and progression of experimental alcoholic liver disease in rats. Hepatology 1992 ;16:1423–7.
- Oh SI, Kim CI, Chun HJ, et al. Chronic ethanol consumption affects glutathione status in rat liver. J Nutr 1998 ;128:758–63.
- Colell A, Garcia-Ruiz C, Miranda M, et al. Selective glutathione depletion of mitochondria by ethanol sensitizes hepatocytes to tumor necrosis factor. Gastroenterology 1998;115:1541–51.
- Adachi Y, Bradford BU, Gao W, et al. Inactivation of Kupffer cells prevents early alcohol-induced liver injury. Hepatology 1994;20:453–60.
- Mathurin P, Deng QG, Keshavarzian A, et al. Exacerbation of alcoholic liver injury by enteral endotoxin in rats. Hepatology 2000;32:1008–17.
- Lands WE. Cellular signals in alcohol-induced liver injury: a review. Alcohol Clin Exp Res 1995;19:928–38.
- Pritchard MT, McMullen MR, Stavitsky AB, et al. Differential contributions of C3, C5, and decay-accelerating factor to ethanol-induced fatty liver in mice. Gastroenterology 2007;132:1117–26.
- Yin M, Wheeler MD, Kono H, et al. Essential role of tumor necrosis factor in alcohol-induced liver injury in mice. Gastroenterology 1999;117:942–52.
- Miller AM, Horiguchi N, Jeong WI, et al. Molecular mechanisms of alcoholic liver disease: innate immunity and cytokines. Alcohol Clin Exp Res 2011;35:787–93.
- Hrubec Z, Omenn GS. Evidence of genetic predisposition to alcoholic cirrhosis and psychosis: twin concordances for alcoholism and its biological end points by zygosity among male veterans. Alcohol Clin Exp Res 1981;5:207–15.
- Nguyen-Khac E, Houchi H, Dupas JL, et al. The -308 TNF gene polymorphism in severe acute alcoholic hepatitis: identification of a new susceptibility marker. Alcohol Clin Exp Res 2008;32:822–8.
- Reed T, Page WF, Viken RJ. Genetic disposition to organ-specific endpoints of alcoholism. Alcohol Clin Exp Res 1996;20:1528–33.
- Tian C, Stokowski RP, Kershenobich D, et al. Variant in PNPLA3 is associated with alcoholic liver disease. Nat Genet 2010;42:21–3.
- Nguyen-Khac E, Houchi H, Dreher ML, et al. Is PNPLA3 polymorphism involved in severe acute alcoholic hepatitis ? Hepatology 2011;54(Suppl. 4):1308.
- Crabb DW, Bataller R, Chalasani NP, et al. Standard definitions and common data elements for clinical trials in patients with alcoholic hepatitis: recommendation from the NIAAA alcoholic hepatitis consortia. Gastroenterology 2016;150:785–90.
- Louvet A, Wartel F, Castel H, et al. Infection in patients with severe alcoholic hepatitis treated with steroids: early response to therapy is the key factor. Gastroenterology 2009;137:541-8.
- Crabb DW, Szabo G, Mellinger JL, et al. Diagnosis and Treatment of Alcohol-Associated Liver Diseases: 2019 Practice Guidance From the American Association for the Study of Liver Diseases. Hepatology 2020;71(1):306-333.
- Hamid R, Forrest EH. Is histology required for the diagnosis of alcoholic hepatitis: a review of published randomized controlled trials. Gut 2011;60:A233.
- Mathurin P, Poynard T, Ramon MJ, et al. Intérêt de la biopsie hépatique : pour la sélection des sujets suspects d’hépatite alcoolique sévère. Gastroenterol Clin Biol 1992;16(Suppl. 2bis):A231.
- Kryger P, Schlichting P, Dietrichson O, et al. The accuracy of the clinical diagnosis in acute hepatitis and alcoholic liver disease. Clinical versus morphological diagnosis. Scand J Gastroenterol 1983;18:691–696.
- Nguyen-Khac E, Cadranel JF, Goichot B, et al. Severe acute alcoholic hepatitis in France (AAH) in 2008: a nationwide survey results (AFEF, ANGH, SNFMI). J Hepatol 2010;52(Suppl. 1):S445.
- Ahn J, Morgan TR, Cohen SM. Evaluation and management of alcoholic hepatitis: a survey of current practices [abstract]. Hepatology 2009;50(Suppl.):651.
- Hall PD. Pathological spectrum of alcoholic liver disease. Alcohol Alcohol Suppl 1994;2:303–13.
- Altamirano J, Miquel R, Katoonizadeh A, et al. A histologic scoring system for prognosis of patients with alcoholic hepatitis. Gastroenterology 2014;146:1231–9.
- Thabut D, Naveau S, Charlotte F, et al. The diagnostic value of biomarkers (AshTest) for the prediction of alcoholic steato-hepatitis in patients with chronic alcoholic liver disease. J Hepatol 2006;44:1175–85.
- Castera L, Hartmann DJ, Chapel F, et al. Serum laminin and type IV collagen are accurate markers of histolo- gically severe alcoholic hepatitis in patients with cirrhosis. J Hepatol 2000;32:412–8.
- Nguyen-Khac E, Hautefeuille V, Godin C, et al. Cytokeratin 18 in severe Acute Alcoholoic Hepatitis. J Hepatol 2012;56(Supple 2): S536.
- Bissonnette J, Altamirano J, Devue C, et al. A prospective study of the utility of plasma biomarkers to diagnose alcoholic hepatitis. Hepatology. 2017;66(2):555-63.
- Maddrey WC, Boitnott JK, Bedine MS, et al. Corticosteroid therapy of alcoholic hepatitis. Gastroenterology 1978;75:193–9.
- Carithers Jr RL, Herlong HF, Diehl AM, et al. Methylprednisolone therapy in patients with severe alcoholic hepatitis. A randomized multicenter trial. Ann Intern Med 1989;110:685–90.
- Sheth M, Riggs M, Patel T. Utility of the Mayo End-Stage Liver Disease (MELD) score in assessing prognosis of patients with alcoholic hepatitis. BMC Gastroenterol 2002;2:2.
- Soultati AS, Dourakis SP, Alexopoulou A, et al. Predicting utility of a model for end stage liver disease in alcoholic liver disease. World J Gastroenterol 2006;12:4020–5.
- Srikureja W, Kyulo NL, Runyon BA, et al. MELD score is a better prognostic model than Child-Turcotte-Pugh score or Discriminant Function score in patients with alcoholic hepatitis. J Hepatol. 2005 May;42(5):700-6. doi: 10.1016/j.jhep.2004.12.022.
- Dunn W, Jamil LH, Brown LS, et al. MELD accurately predicts mortality in patients with alcoholic hepatitis. Hepatology. 2005 Feb;41(2):353-8. doi: 10.1002/hep.20503.PMID: 15660383
- Forrest EH, Evans CD, Stewart S, et al. Analysis of factors predictive of mortality in alcoholic hepatitis and derivation and validation of the Glasgow alcoholic hepatitis score. Gut 2005;54:1174–9.
- Forrest EH, Morris AJ, Stewart S, et al. The Glasgow alcoholic hepatitis score identifies patients who may benefit from corticosteroids. Gut 2007;56:1743–6.
- Dominguez M, Rincón D, Abraldes JG, et al. A new scoring system for prognostic stratification of patients with alcoholic hepatitis. Am J Gastroenterol 2008;103:2747–3756.
- Forrest EH, Fisher NC, Singhal S, et al. Comparison of the Glasgow alcoholic hepatitis score and the ABIC score for the assessment of alcoholic hepatitis. Am J Gastroenterol 2010;105:701–2.
- Moreau R, Jalan R, Gines P, et al. Acute-on-chronic liver failure is a distinct syndrome that develops in patients with acute decompensation of cirrhosis. Gastroenterology. 2013 Jun;144(7):1426-37, 1437.e1-9. doi: 10.1053/j.gastro.2013.02.042. Epub 2013 Mar 6.
- Arroyo V, Moreau R. Diagnosis and prognosis of acute on chronic liver failure (ACLF) in cirrhosis. J Hepatol. 2017 Feb;66(2):451-453.
- Sersté T, Cornillie A, Njimi H, et al. The prognostic value of acute-on-chronic liver failure during the course of severe alcoholic hepatitis. J Hepatol. 2018 Mar 8. pii: S0168-8278(18)30144-2. doi: 10.1016/j.jhep.2018.02.022. [Epub ahead of print]
- Addolorato G, Leggio L, Ferrulli A, et al. Effectiveness and safety of baclofen for maintenance of alcohol abstinence in alcohol-dependent patients with liver cirrhosis: randomised, double-blind controlled study. Lancet 2007;370:1915–22.
- Mendenhall CL, Moritz TE, Roselle GA, et al. Protein energy malnutrition in severe alcoholic hepatitis: diagnosis and response to treatment. The VA Cooperative Study Group. J Parenter Enteral Nutr 1995; 19:258 – 265.
- Plauth M, Cabre E, Riggio O, et al. ESPEN guidelines on enteral nutrition: liver disease. Clin Nutr 2006;25:285–294.
- Cabre E, Rodriguez-Iglesias P, Caballeria J, et al. Short- and long-term outcome of severe alcohol-induced hepatitis treated with steroids or enteral nutrition: a multicenter randomized trial. Hepatology 2000; 32:36 – 42.
- Moreno C, Deltenre P, Senterre C, et al. Intensive enteral nutrition is ineffective for patients with severe alcoholic hepatitis treated with corticosteroids. Gastroenterology 2016; 150:903-10.
- Reynolds TB, Benhamou JP, Blake J, et al. Treatment of acute alcoholic hepatitis. Gastroenterol Int 1989;2:208-16.
- Imperiale TF, McCullough AJ. Do corticosteroids reduce mortality from alcoholic hepatitis? A metaanalysis of the randomized trials. Ann Intern Med 1990;113:299-307.
- Daures JP, Peray P, Bories P, et al. [Corticoid therapy in the treatment of acute alcoholic hepatitis. Results of a meta-analysis]. Gastroenterol Clin Biol 1991;15:223-8.
- Christensen E, Gluud C. Glucocorticoids are ineffective in alcoholic hepatitis: a meta-analysis adjusting for confounding variables. Gut 1995;37:113-8.
- Mathurin P, Mendenhall CL, Carithers RL Jr, et al. Corticosteroids improve short-term survival in patients with severe alcoholic hepatitis (AH): individual data analysis of the last three randomized placebo controlled double blind trials of corticosteroids in severe AH. J Hepatol. 2002 Apr;36(4):480-7.
- Rambaldi A, Saconato HH, Christensen E, et al. Systematic review: glucocorticosteroids for alcoholic hepatitis. a Cochrane Hepato-Biliary Group systematic review with meta-analyses and trial sequential analyses of randomized clinical trials. Aliment Pharmacol Ther 2008;27:1167-78.
- Mathurin P, O’Grady J, Carithers RL, et al. Corticosteroids improve short-term survival in patients with severe alcoholic hepatitis: meta-analysis of individual patient data. Gut 2011;60:255-60.
- Singh S, Murad MH, Chandar AK, et al. Comparative Effectiveness of Pharmacological Interventions for Severe Alcoholic Hepatitis: A Systematic Review and Network Meta-analysis. Gastroenterology 2015;149:958-70 e12.
- Louvet A, Thursz MR, Kim DJ, et al. Corticosteroids Reduce Risk of Death Within 28 Days for Patients With Severe Alcoholic Hepatitis, Compared With Pentoxifylline or Placebo-a Meta-analysis of Individual Data. Gastroenterology 2018 May 5. pii: S0016-5085(18)34495-0. doi: 10.1053/j.gastro.2018.05.011.
- Thursz MR, Richardson P, Allison M, et al. Prednisolone or pentoxifylline for && alcoholic hepatitis. New Engl J Med 2015; 372:1619 – 28.
- Arab JP, Díaz LA, Baeza N, et al. Identification of optimal therapeutic window for steroid use in severe alcohol-associated hepatitis: A worldwide study. J Hepatol. 2021 Nov;75(5):1026-1033. doi: 10.1016/j.jhep.2021.06.019. Epub 2021 Jun 21.PMID: 34166722
- Phillips M, Curtis H, Portmann B, et al. Antioxidants versus corticosteroids in the treatment of severe alcoholic hepatitis – a randomised clinical trial. J Hepatol 2006;44:784–90.
- Moreno C, Langlet P, Hittelet A, et al. Enteral nutrition with or without N-acetylcysteine in the treatment of severe acute alcoholic hepatitis: a randomized multicenter controlled trial. J Hepatol 2010;53:1117–22.
- Stewart S, Prince M, Bassendine M, et al. A randomized trial of antioxidant therapy alone or with corticosteroids in acute alcoholic hepatitis. J Hepatol 2007;47:277–83.
- Nguyen-Khac E, Thevenot T, Piquet MA, et al. Antioxidants plus corticosteroids in the treatment of severe acute alcoholic hepatitis: the question is still open. J Hepatol. 2008 Jul;49(1):147-8; author reply 148.
- Nguyen-Khac E, Thevenot T, Piquet MA, et al. Glucocorticoids plus N-acetylcysteine in severe alcoholic hepatitis. N Engl J Med 2011;365:1781–9.
- Akriviadis E, Botla R, Briggs W, et al. Pentoxifylline improves short-term survival in severe acute alcoholic hepatitis: a double-blind, placebo- controlled trial. Gastroenterology. 2000 Dec;119(6):1637-48.
- Lebrec D, Thabut D, Oberti F, et al. Pentoxifylline does not decrease short-term mortality but does reduce complications in patients with advanced cirrhosis. Gastroenterology 2010; 138:1755 – 62.
- Singal AK, Walia I, Singal A, et al. Corticosteroids and pentoxifylline for the treatment of alcoholic hepatitis: current status. World J Hepatol 2011; 3:205 – 10.
- Sidhu SS, Goyal O, Singla M, et al. Pentoxifylline in severe alcoholic hepatitis: a prospective, randomised trial. J Assoc Physicians India 2012;60:20-2.
- Sidhu SS, Goyal O, Singla P, et al. Corticosteroid plus pentoxifylline is not better than corticosteroidalone for improving survival in severe alcoholic hepatitis (COPE trial). Dig Dis Sci 2012;57:1664-71.
- Mathurin P, Louvet A, Duhamel A, et al. Prednisolone with vs without pentoxifylline and survival of patients with severe alcoholic hepatitis: a randomized clinical trial. JAMA 2013;310:1033-41.
- Park SH, Kim DJ, Kim YS, et al. Pentoxifylline vs. corticosteroid to treat severe alcoholic hepatitis: a randomised, non-inferiority, open trial. J Hepatol 2014;61:792-8.
- Whitfield K, Rambaldi A, Wetterslev J, et al. Pentoxifylline for alcoholic hepatitis. Cochrane Database Syst Rev 2009; CD007339.
- Louvet A, Labreuche J, Dao T, et al. Combination of amoxicillin/clavulanate and prednisolone in severe alcoholic hepatitis: results of the randomized controlled trial Antibiocor. J Hepatol 2021;75(suppl 2): S201.
- Naveau S, Chollet-Martin S, Dharancy S, et al. A double-blind randomized controlled trial of infliximab associated with prednisolone in acute alcoholic hepatitis. Hepatology 2004;39:1390–7.
- Boetticher NC, Peine CJ, Kwo P, et al. A randomized, double-blinded, placebo-controlled multicenter trial of etanercept in the treatment of alcoholic hepatitis. Gastroenterology. 2008 Dec;135(6):1953-60.
- Dubuquoy L, Louvet A, Lassailly G, et al. Progenitor cell expansion and impaired hepatocyte regeneration in explanted livers from alcoholic hepatitis. Gut 2015;64:1949–1960.
- Spahr L, Lambert JF, Rubbia-Brandt L, et al. Granulocyte-colony stimulating factor induces proliferation of hepatic progenitors in alcoholic steatohepatitis: a randomized trial. Hepatology. 2008 Jul;48(1):221-9.
- Singh V, Sharma AK, Narasimhan RL, et al. Granulocyte colony-stimulating factor in severe alcoholic hepatitis: a randomized pilot study. Am J Gastroenterol. 2014 Sep;109(9):1417-23.
- Singh V, Keisham A, Bhalla A, et al. Efficacy of Granulocyte Colony-Stimulating Factor and N-Acetylcysteine Therapies in Patients With Severe Alcoholic Hepatitis. Clin Gastroenterol Hepatol. 2018 Jan 31. pii: S1542-3565(18)30110-1. doi:10.1016/j.cgh.2018.01.040. [Epub ahead of print]
- Spahr L, Chalandon Y, Terraz S, et al. Autologous bone marrow mononuclear cell transplantation in patients with decompensated alcoholic liver disease: a randomized controlled trial. PLoS One. 2013;8(1):e53719. doi: 10.1371/journal.pone.0053719. Epub 2013 Jan 14.
- Philips CA, Pande A, Shasthry SM, et al. Healthy Donor Fecal Microbiota Transplantation in Steroid-Ineligible Severe Alcoholic Hepatitis: A Pilot Study. Clin Gastroenterol Hepatol. 2017 Apr;15(4):600-602. doi: 10.1016/j.cgh.2016.10.029. Epub 2016 Nov 2.
- Sen S, Mookerjee RP, Cheshire LM, et al. Albumin dialysis reduces portal pressure acutely in patients with severe alcoholic hepatitis. J Hepatol. 2005 Jul;43(1):142-8.
- Jalan R, Sen S, Steiner C, et al. Extracorporeal liver support with molecular adsorbents recirculating system in patients with severe acute alcoholic hepatitis. J Hepatol. 2003 Jan;38(1):24-31.
- Boitard J, Louvet A, Bismuth B, et al. Tolerance and efficacy of the mars system in patients with severe alcoholic hepatitis non-responders to steroids: a pilot study. J Hepatol 2008;48 (Supple 2): s355-6.
- Bañares R, Nevens F, Larsen FS, et al. Extracorporeal albumin dialysis with the molecular adsorbent recirculating system in acute-on-chronic liver failure: the RELIEF trial. Hepatology. 2013 Mar;57(3):1153-62.
- Thompson J, Jones N, Al-Khafaji A, et al. Extracorporeal cellular therapy (ELAD) in severe alcoholic hepatitis: A multinational, prospective, controlled, randomized trial. Liver Transpl. 2018 Mar;24(3):380-393.
- Mathurin P, Abdelnour M, Ramond MJ, et al. Early change in bilirubin levels is an important prognostic factor in severe alcoholic hepatitis treated with prednisolone. Hepatology 2003;38:1363–9.
- Louvet A, Naveau S, Abdelnour M, et al. The Lille model: a new tool for therapeutic strategy in patients with severe alcoholic hepatitis treated with steroids. Hepatology 2007;45:1348–54.
- Louvet A, Labreuche J, Artru F, et al. Combining Data From Liver Disease Scoring Systems Better Predicts Outcomes of Patients With Alcoholic Hepatitis. Gastroenterology 2015 Aug;149(2):398-406.
- Mathurin P, Moreno C, Samuel D, et al. Early liver transplantation for severe alcoholic hepatitis. N Engl J Med. 2011 Nov 10;365(19):1790- 800.
- Antonini TM, Guillaud O, Dumortier J, et al. Impact of a first study of early transplantation in acute alcoholic hepatitis: Results of a nationwide survey in french liver transplantation programs. Liver Transpl. 2018 Feb 24. doi: 10.1002/lt.25039.
- Im GY, Kim-Schluger L, Shenoy A, et al. Early liver transplantation for severe alcoholic hepatitis in the United States–a single-Center experience. Am J Transplant. 2016;16:841–849.
- Lee BP, Chen PH, Haugen C, et al. Three-year Results of a Pilot Program in Early Liver Transplantation for Severe Alcoholic Hepatitis. Ann Surg. 2017 Jan;265(1):20-29.
- Lee BP, Mehta N, Platt L, et al. Outcomes of Early Liver Transplantation for Patients With Severe Alcoholic Hepatitis. Gastroenterology. 2018 Apr 12. pii: S0016-5085(18)30442-6. doi: 10.1053/j.gastro.2018.04.009.
- Louvet A, Labreuche J, Moreno C, et al. Early liver transplantation for severe alcoholic hepatitis not responding to medical treatment: Results of the french-belgian prospective study QUICKTRANS. Hepatology 2021; 72(Suppl1); A6.
- Marot A, Dubois M, Trépo E, et al. Liver transplantation for alcoholic hepatitis: A systematic review with meta-analysis. PLoS One. 2018 Jan 11;13(1):e0190823.
- Hmoud BS, Patel K, Bataller R, et al. Corticosteroids and occurrence of and mortality from infections in severe alcoholic hepatitis: a meta- analysis of randomized trials. Liver Int 2016;36:721–728.
- Gustot T, Maillart E, Bocci M, et al. Invasive aspergillosis in patients with severe alcoholic hepatitis. J Hepatol 2014;60:267–274.